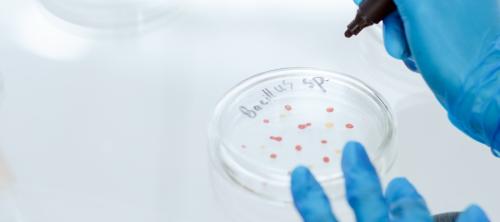

Nueva norma para la validación de métodos de identificación microbiana en alimentos
Enviado por editora el Lun, 07/28/2025 - 08:15En el ámbito de la microbiologia de la cadena alimentaria, la norma UNE-EN ISO 16140-7:2025, publicada este mes de julio, establece el protocolo general y técnico para validar métodos de identificación de microorganismos a partir de colonias aisladas obtenidas de alimentos destinados al consumo humano, piensos, muestras ambientales de zonas de producción o manipulación de alimentos y muestras procedentes de la producción primaria.